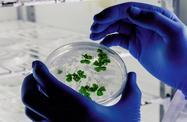
image 9.jpg

BioSolutions UK: Engineering biology to transform industries

The UK is a global leader in driving industrial transformation with engineering biology.
Biosolutions are reshaping the food, agriculture, chemicals, materials, environment and biofuels sectors, powering both economic growth and the transition to Net Zero.
Welcome to BioSolutions UK, the definitive industry event where engineering, biology, and innovation converge to support companies to grow, scale and succeed. Designed for innovators - from start-ups spinning out fresh ideas to large corporates adopting engineering biology - this forum is a launchpad for disruptive ideas, strategic partnerships and scalable biosolutions that tackle real-world challenges.
Join us at BioSolutions UK to connect with fellow disruptors, showcase your biotech and gain insights from leaders shaping the bioeconomy.
Discover how biology is driving real-world solutions to global challenges, and be part of the conversation that’s transforming the future of our planet. Whether you're a startup, scale-up, investor, industrial leader, policymaker or curious mind, BioSolutions UK is your gateway to join the UK’s biorevolution.
Whether you're proving your concept, building at scale or looking to invest into a bio-based future, here is where you find momentum.
The future is bio-engineered.
























